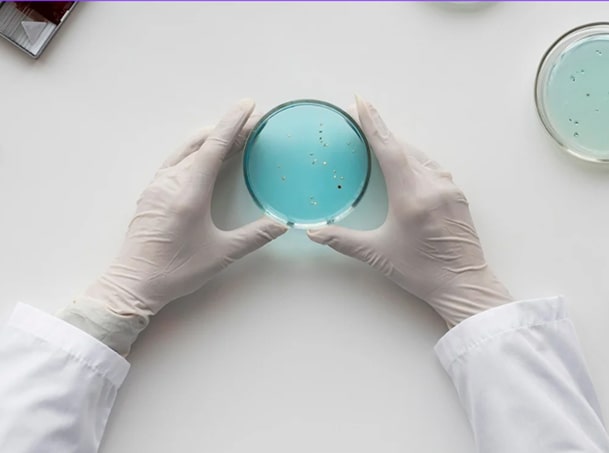

.png)
Una bellezza che nasce dalla scienza
Tutto è iniziato con la visione di Walther Janssen in Germania: creare cosmetici che uniscono scienza e risultati visibili per soddisfare ogni esigenza della pelle.
Dal 1995, la linea è ufficialmente riconosciuta come Cosmeceutica, un traguardo che testimonia la qualità e l’efficacia dei suoi trattamenti.
Soluzioni Cosmeceutiche all’avanguardia
Uniamo scienza e innovazione per creare soluzioni cosmetiche avanzate che rispettano la pelle e agiscono efficacemente su vari tipi di inestetismi.

Massima Sicurezza
I test clinici garantiscono il massimo dei risultati anche sulle pelle più sensibili, senza irritare.
Tecnologie Avanzate
Metodologie scientifiche brevettate garantiscono risultati visibili da subito e duraturi.

Rispetto per l’ambiente
Ci impegniamo a ridurre l’impatto ambientale scegliendo solo ingredienti biotecnologici

Ricerca Continua
Ricerchiamo costantemente di nuove tecnologie e formulazioni per soddisfare le esigenze di ogni tipo di pelle.
Formulazioni studiate con dermatologi
Grazie alla stretta collaborazione con stimati dermatologi e laboratori di ricerca all’avanguardia, JANSSEN COSMETICS è riuscita a creare un approccio cosmetico serio e innovativo che soddisfa le molteplici esigenze e diversità della pelle.

0% Ingredienti potenzialmente irritanti

100% Cruelty Free


La Biotecnologia a sostegno dell’ambiente e degli animali
Da sempre, JANSSEN COSMETICS sceglie il meglio della ricerca biotecnologica per garantire ingredienti sicuri, efficaci e sostenibili.
Grazie a processi avanzati, i suoi attivi offrono prestazioni elevate e qualità costante, supportate da studi scientifici rigorosi.
Il risultato? Formulazioni CRUELTY FREE, efficaci e prive di ingredienti irritanti.

Principi attivi di derivazione biotecnologica per la sicurezza e l'efficacia degli ingredienti

Trattamenti di successo in oltre 85 paesi in tutto il mondo

Riduzione di CO2
Operiamo con diligenza per ridurre la produzione di Co2 durante tutto il ciclo produttivo fino alla spedizione ai clienti del prodotto.

Packaging Riciclabile
Limitare il consumo di plastica non è solo una scelta, ma una responsabilità. Utilizzando packaging riciclabili, riduciamo l’impatto ambientale, abbassiamo la produzione di rifiuti e diamo nuova vita ai materiali già esistenti, evitando l’estrazione di nuove risorse.

Rispetto per l’ambiente
Risparmiamo fino al 50% di energia, produciamo in modo 100% CO₂ neutrale e lavoriamo per raggiungere emissioni zero. Ogni scelta che facciamo oggi costruisce un domani più pulito e responsabile, insieme.

Linee professionali per il tuo Istituto di Bellezza
Non solo skincare domiciliare, ma protocolli professionali per il tuo Istituto di Bellezza.
Offri alle tue clienti trattamenti mirati, efficaci e piacevoli, combinando scienza e benessere. Richiedi le ultime novità per arricchire la tua proposta in cabina e garantire risultati visibili e duraturi.

